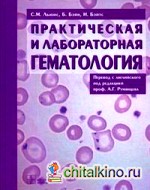
Практическая и лабораторная гематология

|
|
|
|
| |
Бейн Б. Дж.
|

|
Хронические миелоидные лейкозы: Атлас-справочник
Автор: Бейн Б. Дж. Жанр: Справочники и энциклопедии Издательство: Медпрактика-М Год: 2014 Страниц: 64 Дата загрузки: 10 сентября 20192019-08-27
|
|
Атлас-справочник в сжатой, но очень наглядной форме описывает патогенез, симптоматику, диагностику и дифференциальную диагностику, а также лечение хронических миелоидных лейкозов — большой и разнообразной группы болезней, недостаточно знакомых практическим врачам.
|
| |
|
Практическая и лабораторная гематология
Автор: Бэйн Б.Дж. Жанр: Онкология. Гематология Издательство: ГЭОТАР-Медиа Год: 2009 Страниц: 672 Дата загрузки: 10 сентября 20142012-04-22
|
|
Руководство уже более 50 лет является стандартом по лабораторной гематологии в США и Западной Европе. Авторы подробно описывают методики лабораторного обследования больных с заболеваниями крови и интерпретацию полученных результатов, принципы организации и управления работой гематологической лаборатории, а также освещают вопросы контроля за качеством проводимых исследований. Руководство может служить настольной книгой для заведующих лабораториями, врачей-гематологов, лаборантов, а также справочником по качественной лабораторной практике для руководящего звена учреждений здравоохранения.
|
| |
|
|
|
|
|
